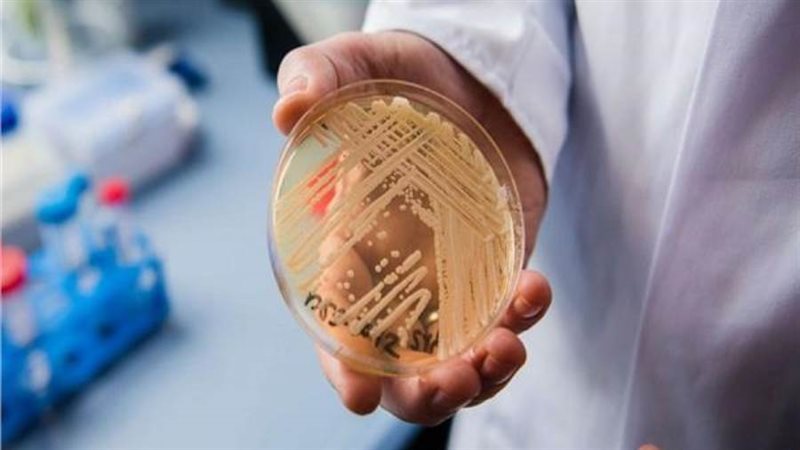

الفطر القاتل.. رعب جديد يطرق أبواب العالم من «البوابة الأمريكية»
تعيش الولايات المتحدة الأمريكية، تحت رحمة فطر نادر وقاتل في كثير من الأحيان ينتشر بسرعة في جميع أنحاء البلاد، مما يزيد الضغط لإيجاد علاجات جديدة لهذا المرض الفطري الحاد.
وقالت مراكز السيطرة على الأمراض والوقاية منها بالولايات المتحدة، إن فطر كانديدا أوريس، وهو فطر اكتشف قبل حوالي 15 عامًا في اليابان، أصاب ما لا يقل عن 2377 شخصًا في الولايات المتحدة في عام 2022، ارتفاعًا من 53 في عام 2016.
ووفقًا لصحيفة وول ستريت جورنال فقد أدى انتشار الفطر السريع في معظم الولايات وأكثر من 40 دولة إلى دفع مركز السيطرة على الأمراض ومنظمة الصحة العالمية إلى وصفه بأنه تهديد متزايد للصحة العامة.
وأكدت مراكز السيطرة على الأمراض والوقاية منها، أن فطر كانديدا أوريس لديه معدل وفيات يصل إلى 60٪ وهي محفوفة بالمخاطر بشكل خاص للأشخاص الأكبر سنًا أو الذين يعانون من ضعف في جهاز المناعة.
وكان باحثو مركز السيطرة على الأمراض (CDC)، كشفوا في دراسة نشرت الاثنين في دورية حوليات الطب الباطني، عن أن أول إصابة بهذا الفطر موثقة في الولايات المتحدة كانت في عام 2013.
وقالت الدراسة إن الفطر وسع نطاقه منذ ذلك الحين من مراكز انتشار في جميع أنحاء مدينة نيويورك وشيكاغو إلى ما لا يقل عن 28 ولاية وواشنطن العاصمة.
الدكتورة ميجان لايمان، عالمة الأوبئة في مركز السيطرة على الأمراض والمؤلفة الرئيسية ذكرت في الورقة البحثية أيضًا: «كانت رؤية عدد الحالات مقلقة».